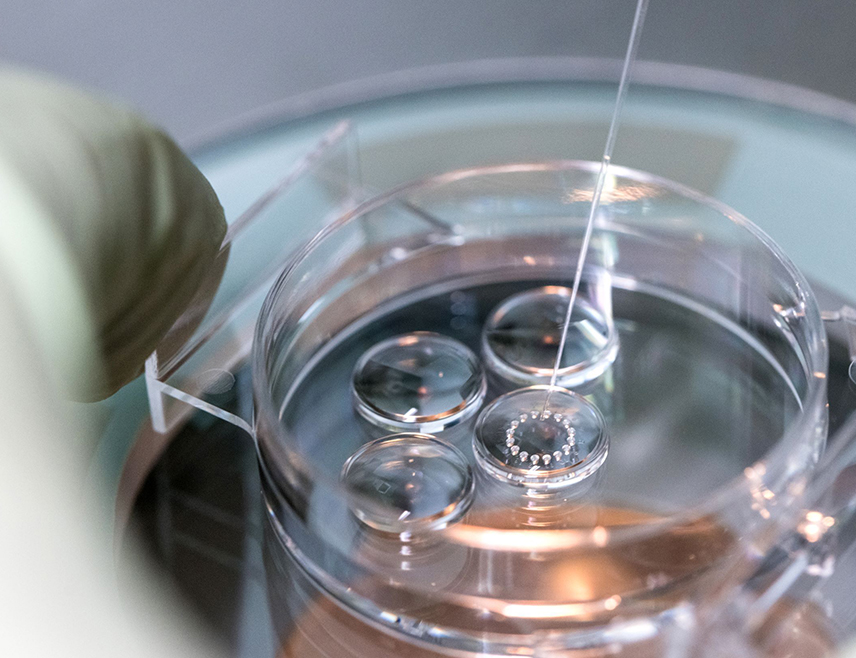
ПРИЈЕДОР, 6. ФЕБРУАРА /СРНА/ - Град Приједор донио је нови правилник о расподјели средстава за подршку пронаталитетној политици којим је износ једнократне помоћи женама за вантјелесну оплодњу увећан са 5.500 на 6.500 КМ, а доб жена са 42 на 48 година.

Република Српска
06.02.2026

ЗА ВАНТЈЕЛЕСНУ ОПЛОДЊУ УВЕЋАНИ ИЗНОС ПОМОЋИ И СТАРОСНА ГРАНИЦА
ПРИЈЕДОР, 6. ФЕБРУАРА /СРНА/ - Град Приједор донио је нови правилник о расподјели средстава за подршку пронаталитетној политици којим је износ једнократне помоћи женама за вантјелесну оплодњу увећан са 5.500 на 6.500 КМ, а доб жена са 42 на 48 година.
Право могу остварити жене са пребивалиштем у Приједору у непрекидном трајању дужем од једне године прије подношења захтјева и којима је признато ово право, те имају реализоване три процедуре асистиране репродукције на терет Фонда здравственог осигурања Рeпублике Српске, као и препоруку клинике или љекара за наредну процедуру вантјелесне оплодње. Женама које имају од 40 до 42 године, а којима је Фонд здравственог осигурања Републике Српске финансирао 50 одсто трошкова поступка вантјелесне оплодње, имају право на преосталих 50 одсто од Градске управе. Уколико жена има више од 42 године, а први пут иде на поступак вантјелесне оплодње, има право на суфинансирање од Градске управе. Новина је и да један од чланова комисије која одлучује о овом праву мора бити специјалиста гинекологије и акушерства. Јавни позив о расподјели средстава за подршку пронаталитетној политици расписује Градска управа једном у току године и тај позив остаје отворен до краја те године.
Република Српска


СУТРА БЛАГОВИЈЕСТИ
БИЈЕЉИНА, 6. АПРИЛА /СРНА/ - Српска православна црква /СПЦ/ прославиће сутра Благовијести, празник којим се прославља догађај када је Арханђео Гаврило...


ПОЧИЊЕ ИСПИТИВАЊЕ КОЛОВОЗНЕ КОНСТРУКЦИЈЕ НА ДИОНИЦИ ГЛАМОЧАНИ-МАХОВЉАНСКА ПЕТЉА
БАЊАЛУКА, 6. АПРИЛА /СРНА/ - На дионици ауто-пута Гламочани-Маховљанска петља данас почиње испитивање коловозне конструкције које ће трајати 10 дана,...


МАСТИЛОВИЋ У ФОЧИ У ПОСЈЕТИ ФАКУЛТЕТИМА, БОГОСЛОВИЈИ И СТУДЕНТСКОМ ЦЕНТРУ
БАЊАЛУКА, 6. АПРИЛА /СРНА/ - Министар за научнотехнолошки развој и високо образовање Републике Српске Драга Мастиловић боравиће данас у Фочи гдје ће п...


ПРЕДАВАЊЕ О ЗАШТИТИ ЛИЧНИХ ПОДАТАКА У ВИСОКОМ ОБРАЗОВАЊУ
БАЊАЛУКА, 6. АПРИЛА /СРНА/ - У Бањалуци ће данас бити одржано предавање о теми "Обрада и заштита личних података у високом образовању: кључне обавезе...


ШЕРАНИЋ У ПРИЈЕДОРУ
БАЊАЛУКА, 6. АПРИЛА /СРНА/ - Министар здравља и социјалне заштите Републике Српске Ален Шеранић посјетиће данас Приједор, гдје ће разговарати са градо...


ДОЈАВА О БОМБИ У БАЊАЛУЧКОЈ СРЕДЊОЈ ШКОЛИ
БАЊАЛУКА , 6. АПРИЛА /СРНА/ - Средња школа у Бањалуци добила је јутрос дојаву о постављној експлозивној направи и у току је противдиверзиони преглед о...





 НАЈНОВИЈЕ ВИЈЕСТИ:
НАЈНОВИЈЕ ВИЈЕСТИ: